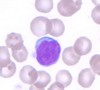

Hematology Flashcards
Neme the hierarchy of blood cells (lineage).
Top to bottom: Multipotent Stem Cell,
Primitive Progenitor Cell,
Committed Precursor Cell,
Lineage Committed Cell
platelet, erythrocyte, neutrophil, basophil, eosinophil, monocyte, T-cell, B-cell, NK cell
What is the functional stimulus for increased production of EPO?
Hypoxia.
Describe the life of an erythrocyte. What are the lifespans of RBC’s in the dog, horse, cat, cow, mice? What are the end products and where do they end up?
~5 days in production inside BM. ~2 days maturation in bloodstream from Reticulocyte to mature RBC (except horse - they mature in BM) ~65-140 days in circulation until removed by spleen Mouse: ~43 days Cat: ~70 days Dog: ~120 days Cow: ~130 days Horse: ~145 days Iron back to BM. Bilirubin to liver, then excreted as bile into GIT. Proteins - circulation? excreted?
What is granulopoiesis? Where does it take place? How long does it take?
Production and maturation of granulocytes in the BM. 6 days.
What are the pools of neutrophils in the BM? blood? Which pool(s) is/are picked up on blood sampling?
Mitotic (proliferating), Maturation (post mitotic), and Storage pools in BM Circulating neutrophil pool. Marginating neutrophil pool. only circulating pool picked up on sampling.
MCV?
Mean Cell Volume
MCHC?
Mean Cellular Hemoglobin Concentration
RDW?
Red Cell Distribution Width
Normoblasts?
Nucleated RBC’s
Where are the hematopoetic tissues in the fetus? Adult?
Fetus: yolk sac, liver, spleen, bone marrow Adult: Bone marrow
Name this cell

Neutrophil
Name this cell

monocyte
Name this cell
lymphocyte
Name this cell

eosinophil
Name this cell

basophil
List the cell lineage of erythropoiesis. ID the first recognizable cell. What is the first cell to be lacking a nucleus? Which cells belong to the proliferating mitotic pool? Which cells belong to the post-mitotic pool?
- Multipotent Stem Cell
- Unipotent Stem Cell
- Rubriblast
- Prorubricyte
- Rubriyte
- Metarubricyte
- Reticulocyte
- Erythrocyte
First recognizable cell is the Rubriblast / pro-erythroblast.
First cell lacking a nucleus is the Reticulocyte
Proliferating Mitotic Pool - early cells: Multipotent to Rubricyte
Post-mitotic Pool - Metarubricyte to Erythrocyte
Do horses release immature RBCs?
Is Rouleaux formation a sign of dz or normal?
No.
Can be a normal finding.
List the cell lineage for granulopoiesis.
What is the first recognizable cell?
What is the first cell that allows differentiation of lineage? How is it possible to differentiate?
Which cells belong to the proliferating mitotic pool? Maturational post-mitotic pool? Storage pool?
- Multipotent stem cell
- Unipotent stem cell
- Myelobblast
- Promyelocyte
- Myelocyte
- Metamyelocyte
- Band Neutrophil
- Mature Neutrophil
First recognizable cell is the myeloblast.
Diff of cell lineage - Myelocyte. Based on specific granulation.
Proliferating mitotic pool - Multipotent stem cell to Myelocyte
Maturational post-mitotic pool - Metamyelocyte to Band Neutrophil
Storage pool - mature neutrophil
What is different about a rabbits hematolgy?
They have more reticulocytes than a dog/cat. Their RBCs have a shorter lifespan.
Reference intervals?
Describes the range of results expected for a healthy population of animals.
Central 95% of population.
Specific for instrument, lab, animal spp.
Why is a smear report important?
verification of the analyzers findings
ID artifacts like platelet clumping, cell lysis
ID morphological changes, abnormal cells, parasites.
What are some clinical features of Acute Anemia?
- Pallor/pale MM
- Tachycardia
- Muscular Weakness
- Subnormal Temp
- Coma
- Death
What are some clinical features of Chronic Anemia?
- Fatigue/lethargy
- Exercise Intolerance
- Tachycardia
- Fainting
- Pallor
- Cardiac Murmor (hypoviscous blood = increased turbulance)
What are the two broad categories of anemia?
- Non-regenerative - decreased production of RBCs
- Regenerative - increased loss of RBCs


